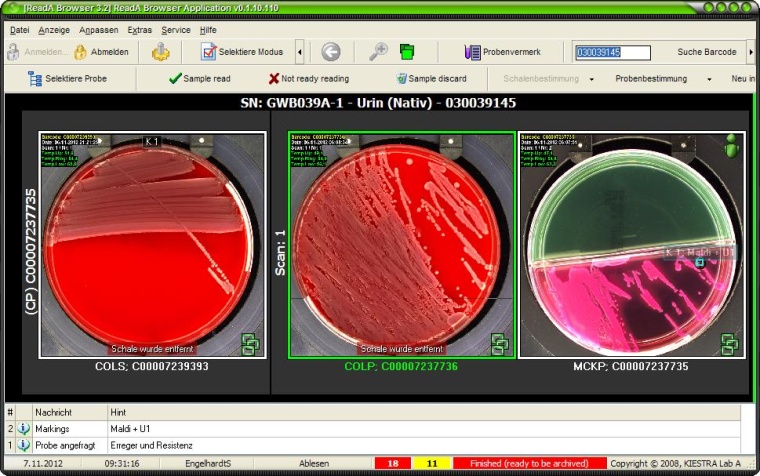
Abb. 2: Urinkulturplatten im ReadA-Browser von Kiestra. Agarplatten werden...

Die Bedeutung der Klinischen Mikrobiologie für das Krankenhaus

Infektionskrankheiten haben einen hohen Stellenwert für im Krankenhaus behandelte Patienten. In Deutschland werden jährlich 200000 Patienten mit einer ambulant erworbenen Pneumonie, mehr als 150.000 wegen einer Sepsis stationär behandelt.
Hinzu kommt eine sehr viel größere Zahl von Patienten, die z. B. wegen Haut- und Weichteilinfektionen, Exazerbationen einer chronisch obstruktiven Lungenerkrankung, Peritonitis, infektiöser Diarrhöe, komplizierter Harnwegsinfektionen, Reiseerkrankungen und opportunistischer Infektionen bei Immunsuppression stationär behandelt werden. Zusätzlich erkranken in Deutschland jährlich 400 - 600.000 Patienten während eines stationären Aufenthalts an einer im Krankenhaus erworbenen Infektion: am häufigsten sind postoperative Wundinfektionen (24,7 %), Harnwegsinfektionen (22,4 %), untere Atemwegsinfektionen (21,5 %), Clostridium difficile-assoziierte Diarrhöe (6,6 %) und primäre Sepsis (6,0 %). Jährlich sterben in deutschen Krankenhäusern 10-15.000 Patienten an einer nosokomialen Infektion. Es wird angenommen, dass 20-30 % der nosokomialen Infektionen vermeidbar wären. Die Bedeutung von Infektionen im Krankenhaus zeigt auch, dass fast ein Viertel aller Patienten in einer repräsentativen Stichprobe deutscher Kliniken mit Antibiotika behandelt wurden.
Wirksame Antibiotika und Antimykotika sind Eckpfeiler einer erfolgreichen modernen Medizin. Viele therapeutische Verfahren werden immer invasiver und die Patienten durch die Veränderungen in der Altersstruktur aber auch durch Multimorbidität und iatrogene oder erworbene Abwehrschwäche immer anfälliger für infektiöse Komplikationen. Die erfolgreiche Waffe „Antiinfektiva" droht stumpf zu werden. Waren in den 90er Jahren insbesondere Gram-positive Erreger wie MRSA und Vancomycin-resistente Enterokokken (VRE) Problemkeime, sind im zweiten Jahrzehnt des 21. Jahrhunderts zusätzlich multiresistente Gram-negative Stäbchenbakterien mit Extended-Spektrum-ß-Lactamasen (ESBL) und Carbapenemasen wie Escherichia coli, Klebsiella pneumoniae, Pseudomonas aeruginosa und Acinetobacter baumannii von zunehmender Bedeutung. Die Entwicklung neuer Antibiotika ist in den nächsten Jahren, insbesondere für diese Problemkeime, nicht zu erwarten, da die Pipeline der Entwicklung in der Industrie ausgetrocknet ist. Deshalb sind wir darauf angewiesen, mit dem vorhandenen Arsenal auszukommen und dieses entgegen der zunehmenden Antibiotika-Resistenzentwicklung wirksam zu erhalten.
Infektionsschutzgesetz
Dem trägt auch der Gesetzgeber im §23 Infektionsschutzgesetz Rechnung, der durch die KRINKO neue Empfehlungen zum Umgang mit Patienten mit multiresistenten Gram-negativen Stäbchenbakterien, den sogenannten MRGN, erlassen hat. Dies betrifft direkt die Verantwortlichkeit der Leiter von Krankenhäusern, die verpflichtet sind, die Umsetzung der entsprechenden Maßnahmen in ihrem Verantwortungsbereich sicherzustellen. Die Identifizierung des verantwortlichen Erregers bei Infektionen oder von Erregern mit besonderen Resistenzen haben direkte, erlösrelevante Konsequenzen durch entsprechend dotierte Haupt- oder Nebendiagnosen, die im Rahmen des DRG-Systems kodiert werden können.
Der Klinische Mikrobiologe und die Krankenhausärzte sind Partner bei der Lösung dieser vielfältigen Probleme. Dies erfordert eine regelmäßige und umfassende Kommunikation, vorwiegend telefonisch. Das Bioscientia Labor Ingelheim bietet in diesem Rahmen Infektionsdiagnostik mit modernsten Verfahren einschließlich MALDI-TOF Massenspektrometrie zur Erregeridentifizierung, molekularbiologische Erregeridentifizierung, sowie einer der ersten Automatisierungen (Kiestra) in der Mikrobiologie in Europa. Abbildung 1 zeigt einen solchen integrierten Arbeitsplatz im Labor, der die technischen Mitarbeiter maximal unterstützt, schnellstmöglich, verlässlich und reproduzierbar Erregeridentifizierung und Resistenzbestimmung nach den Empfehlungen nationaler und internationaler Fachgesellschaften durchzuführen. Das Kiestra-System fotografiert Kulturen automatisch, die dauerhaft für eine virtuelle infektiologische Visite zur Verfügung stehen (Abb. 2). Hinzu kommen der molekularbiologische Erregernachweis, die Mykobakterien-(TB)-diagnostik einschließlich Kultur, molekularem Nachweis und Resistenzbestimmung sowie die infektionsserologische Diagnostik. Die Zusammenarbeit von Spezialisten aus Bakteriologie, Virologie, Mykologie und Parasitologie ermöglicht eine Infektionsdiagnostik aus einer Hand, die in ihrer klinischen Relevanz durch die enge Kooperation mit dem Bioscientia Zentrum für Hygiene und Infektionsprävention (ZHI) ergänzt wird.
Auf dieser Basis bietet der Klinische Mikrobiologe Beratung für das Management komplexer Fälle bezüglich der empfehlenswerten Diagnostik und der dafür erforderlichen Materialien einschließlich besonderer Präanalytik sowie für das Therapie- und Hygienemanagement im Einzelfall. Der Autor war einer der ersten Klinischen Mikrobiologen in Deutschland, der regelmäßige klinische Visiten auf Intensivstationen seiner Klinik etabliert hat. Andere Kollegen in der Abteilung verfügen z. B. über eine zusätzliche Facharztanerkennung als Internist und kennen so die klinischen Probleme auch aus eigener Anschauung. Bei Nachweis von multiresistenten Erregern kann im Konsil mit dem behandelnden Kollegen Besiedelung von Infektion abgegrenzt werden und die Entscheidung für oder gegen eine Therapie getroffen werden. Bei Therapiebedarf hilft der klinische Mikrobiologe anhand der differenzierten Resistenzbestimmung (MHK-Werte) eine Kombinationstherapie zu finden, die am ehesten noch Aussicht auf Erfolg bietet. Bei Verdacht auf Gelenkprothesen-Infekt können im Gespräch mit dem Chirurgen die kulturellen Befunde einschließlich der Kultur-Bilder im Zusammenhang mit den histopathologischen Befunden besprochen und die Entscheidung Infektion oder blande Lockerung auf Grund dieser Informationen und dem OP-Befund getroffen werden. Bei infektiöser Endocarditis mit ungewöhnlichen Erregern fällt die Diagnose oft erst in der Zusammenschau auf, da Einzelisolierungen gewöhnlich als Kontamination gedeutet werden.
Der Klinische Mikrobiologe hilft auch bei der Definition der lokalen Epidemiologie und Resistenzlage durch jährliche Resistenzstatistiken und Listen mit aufzeichnungspflichtigen Erregern (§23 IfSG). Bioscientia ist darüber hinaus auch an überregionalen Projekten zur Überwachung der Resistenzlage in Deutschland wie der Antibiotika-Resistenz-Surveillance (ARS) beim Robert-Koch-Institut oder den Resistenzstudien der Paul-Ehrlich-Gesellschaft aktiv.
Anbieter
Bioscientia Institut für Medizinische Diagnostik GmbHKonrad-Adenauer-Straße 17
55218 Ingelheim
Deutschland
Meist gelesen

Neues Sequenzier-Labor am Krankenhaus Merheim eröffnet
Das Krankenhaus Merheim der Kliniken der Stadt Köln hat am 7. Oktober 2025 offiziell sein neues Sequenzier-Labor in Betrieb genommen – ein bedeutender Schritt in Richtung moderner, personalisierter Krebsmedizin.

Pro Care 2026 - Die Fachmesse für Kliniken und Pflegeeinrichtungen
Pro Care: vom 10.–11. Februar 2026 auf dem Messegelände Hannover: Erleben Sie Digitalisierung, Lösungsansätze zur Entlastung und für die Zukunft der Pflege.

Zukunftsfähig: Neuausrichtung des TAVI-Programms im Asklepios St. Georg
Mit der Prozessoptimierung des TAVI-Programms gelang es dem Team für strukturelle Herzerkrankungen, wirtschaftliche Effizienz und Mitarbeiterzufriedenheit zu steigern – ein Gewinn für alle Seiten.

Richtiges Händewaschen: Die Temperatur ist nicht entscheidend
Welchen Einfluss hat die Wassertemperatur, die Waschdauer und die Wassermenge auf das Händewaschen? Zwei Studien der Medizinischen Universität Wien zeigen überraschende Ergebnisse.

Pro Care 2026 zeigt innovative Versorgungslösungen aus der Hauswirtschaft
Pflegequalität entsteht nicht nur am Pflegebett, sondern in allen Bereichen des Alltags, die das Leben in einer Einrichtung prägen.









